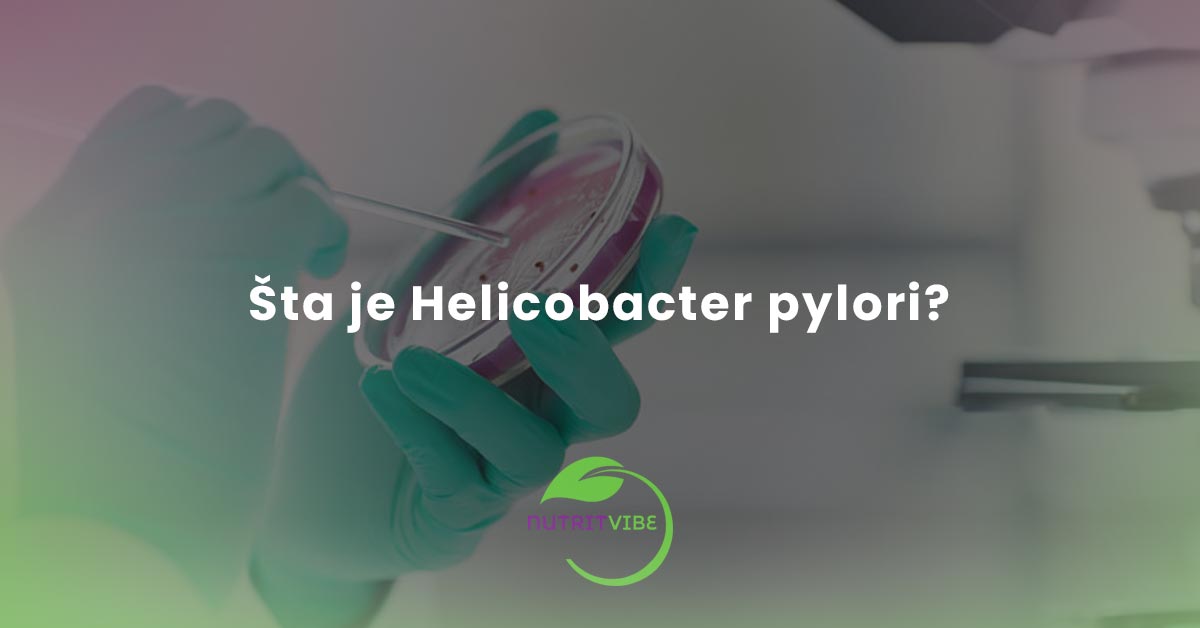

by Semira Karijasevic | feb 5, 2025 | Zdravlje
Nutricionista online Inzulinska rezistencija predstavlja stanje u kojem tjelesne ćelije stanice smanjuju svoju osjetljivost na hormon inzulin, što rezultira smanjenom učinkovitošću u preuzimanju glukoze iz krvi. Inzulinska rezistencija je tiha, ali ozbiljna prijetnja...

by Semira Karijasevic | aug 9, 2024 | Ishrana, Zdravlje
Briga o zdravlju djeteta počinje već u prenatalnom periodu, kada majka svjesno bira nutritivno bogatu hranu koja osigurava optimalan rast i razvoj bebe. Ova pažljiva selekcija hrane postavlja temelje za zdravlje koje će pratiti dijete tokom cijelog života. Nakon...

by Semira Karijasevic | jul 18, 2024 | Zdravlje
Helicobacter pylori (H. pylori) je gram-negativna, spiralna bakterija koja inficira želudac. Ova bakterija je jedan od glavnih uzroka gastritisa, peptičkog ulkusa i može doprinijeti razvoju raka želuca. Infekcija se najčešće javlja u djetinjstvu i može trajati čitav...

by Semira Karijasevic | jun 14, 2024 | Zdravlje
Da li ste ikada istraživali koliko je zapravo važan jod? Jod je ključan mineral za naše zdravlje, a u ovom blogu istražit ćemo njegov značaj i kako ga unosimo kroz ishranu. Saznajte koje su to namirnice bogate jodom i kako ovaj element utiče na rad štitne žljezde i...

by Semira Karijasevic | jun 9, 2024 | Zdravlje
Inzulinska rezistencija je stanje u kojem tijelo ne reaguje dobro na hormon inzulin. Inzulin je hormon koji pomaže glukozi (šećeru) iz krvi da uđe u ćelije, gdje se koristi za energiju.Sva tkiva sa inzulinskim receptorima mogu postati rezistentna na inzulin, ali tkiva...

by Semira Karijasevic | jun 5, 2024 | Ishrana, Zdravlje
Šta je Hrono ishrana i šta su hrono restrikcije? Hrono ishrana je pristup ishrani koji se temelji na sinhronizaciji unosa hrane sa unutrašnjim tjelesnim satom, poznatim kao cirkadijalni ritmovi. Ovi ritmovi upravljaju mnogim procesima u tijelu, uključujući...